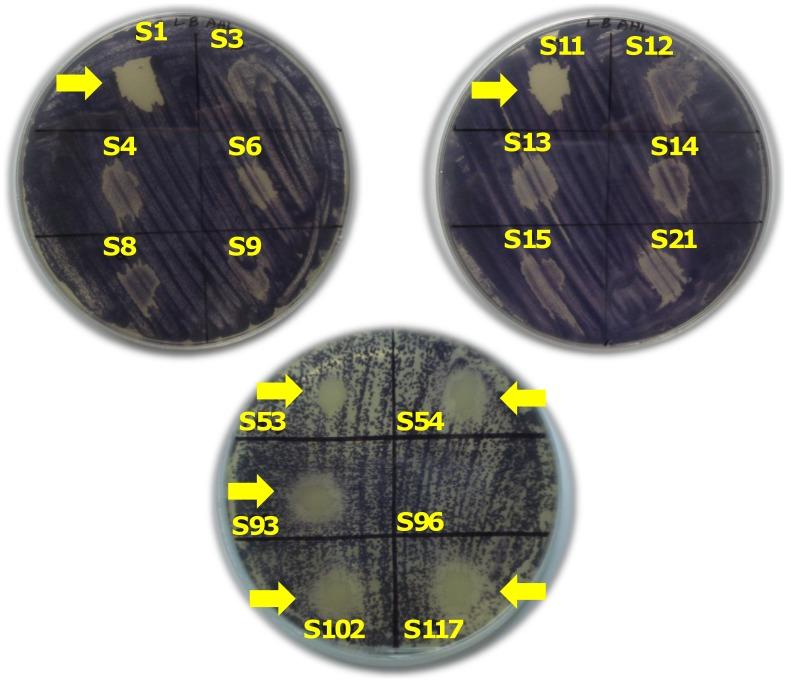
https://cdn.ncbi.nlm.nih.gov/pmc/blobs/0efb/3398020/3ee9d02c94cb/pone.0036696.g002.jpg

检测群体感应信号分子并鉴定生物膜形成的不动杆菌临床分离株中的自体诱导物合成酶基因
Detection of quorum sensing signal molecules and identification of an autoinducer synthase gene among biofilm forming clinical isolates of Acinetobacter spp.
机构信息
Department of Medical Microbiology, Faculty of Medicine, University of Malaya, Kuala Lumpur, Malaysia.
出版信息
PLoS One. 2012;7(7):e36696. doi: 10.1371/journal.pone.0036696. Epub 2012 Jul 16.
BACKGROUND
Quorum sensing is a term that describes an environmental sensing system that allows bacteria to monitor their own population density which contributes significantly to the size and development of the biofilm. Many gram negative bacteria use N-acyl-homoserine lactones as quorum sensing signal molecules. In this study, we sought to find out if the biofilm formation among clinical isolates of Acinetobacter spp. is under the control of autoinducing quorum sensing molecules.
METHODOLOGY/PRINCIPAL FINDINGS: Biofilm formation among clinical isolates of Acinetobacter spp. was assessed and the production of signal molecules were detected with Chromobacterium violaceum CV026 biosensor system. Characterisation of autoinducers was carried out by mass spectrometric analysis. We have also reported the identification of an autoinducer synthase gene, abaΙ among the isolates that produce quorum sensing signal molecules and have reported that the mutation in the abaI gene influences their biofilm forming capabilities. Using a microtitre-plate assay it was shown that 60% of the 50 Acinetobacter spp. isolates significantly formed biofilms. Further detection with the biosensor strain showed that some of these isolates produced long chain signal molecules. Mass spectrometric analysis revealed that five of these isolates produced N-decanoyl homoserine lactone and two isolates produced acyl-homoserine lactone with a chain length equal to C(12). The abaΙ gene was identified and a tetracycline mutant of the abaΙ gene was created and the inhibition in biofilm formation in the mutant was shown.
CONCLUSIONS/SIGNIFICANCE: These data are of great significance as the signal molecules aid in biofilm formation which in turn confer various properties of pathogenicity to the clinical isolates including drug resistance. The use of quorum sensing signal blockers to attenuate bacterial pathogenicity is therefore highly attractive, particularly with respect to the emergence of multi antibiotic resistant bacteria.
背景
群体感应是一个术语,用于描述一种环境感应系统,该系统使细菌能够监测其自身的种群密度,这对生物膜的大小和发育有重要贡献。许多革兰氏阴性菌使用 N-酰基高丝氨酸内酯作为群体感应信号分子。在这项研究中,我们试图了解临床分离的不动杆菌属生物膜形成是否受自动诱导群体感应分子的控制。
方法/主要发现:评估了临床分离的不动杆菌属生物膜的形成,并使用 Chromobacterium violaceum CV026 生物传感器系统检测信号分子的产生。通过质谱分析对自动诱导物进行了表征。我们还报告了在产生群体感应信号分子的分离物中发现了一种自动诱导物合成酶基因 abaΙ,并报告了 abaI 基因的突变影响其生物膜形成能力。使用微量滴定板测定法表明,50 株不动杆菌属分离物中有 60%显著形成生物膜。用生物传感器株进一步检测表明,其中一些分离物产生了长链信号分子。质谱分析显示,其中 5 株分离物产生了 N-癸酰高丝氨酸内酯,2 株分离物产生了链长等于 C(12)的酰基高丝氨酸内酯。鉴定了 abaΙ 基因,并创建了 abaΙ 基因的四环素突变体,并显示突变体中生物膜形成受到抑制。
结论/意义:这些数据非常重要,因为信号分子有助于生物膜的形成,进而赋予临床分离物各种致病性特性,包括耐药性。因此,使用群体感应信号阻滞剂来减弱细菌的致病性具有很高的吸引力,特别是考虑到多抗生素耐药细菌的出现。